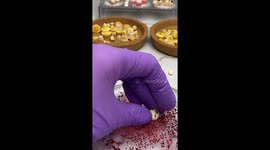

A Bundle is already in your cart
You can only have one active bundle against your account at one time.
If you wish to purchase a different bundle please remove the current bundle from your cart.
You have unused credits
You still have credits against a bundle for a different licence. Once all of your credits have been used you can purchase a newly licenced bundle.
If you wish to purchase a different bundle please use your existing credits or contact our support team.
Appears in Newsflare picks
01:02
Innovative chef's Grilled Okra extravaganza is a culinary spectacle
Whether you're a fan of okras or not, this mouth-watering montage will, without a doubt, leave you craving some!
Watch as Tufan Basal takes you on a culinary journey, demonstrating the art of crafting Grilled Okra.
The way the gifted chef transforms fresh okra into tangy, smoky delights through the magic of grilling is a treat for the eyes and a tantalizing symphony for the taste buds.
"It's the most delicious form of okra, and it can be used in jars for up to three years," Tufan revealed to WooGlobe.
Name: Tufan Basal
Location: Ankara, Turkey
Filmed on: 2023-08-22
Categories
From the blog
Stories not Stock: 3 Reasons Why You Should Use UGC Instead of Stock Video
Video content is an essential part of a brand’s marketing strategy, and while stock footage has been a reliable go-to in the past, forward-thinking companies are looking to user-generated content for their video needs.
View post